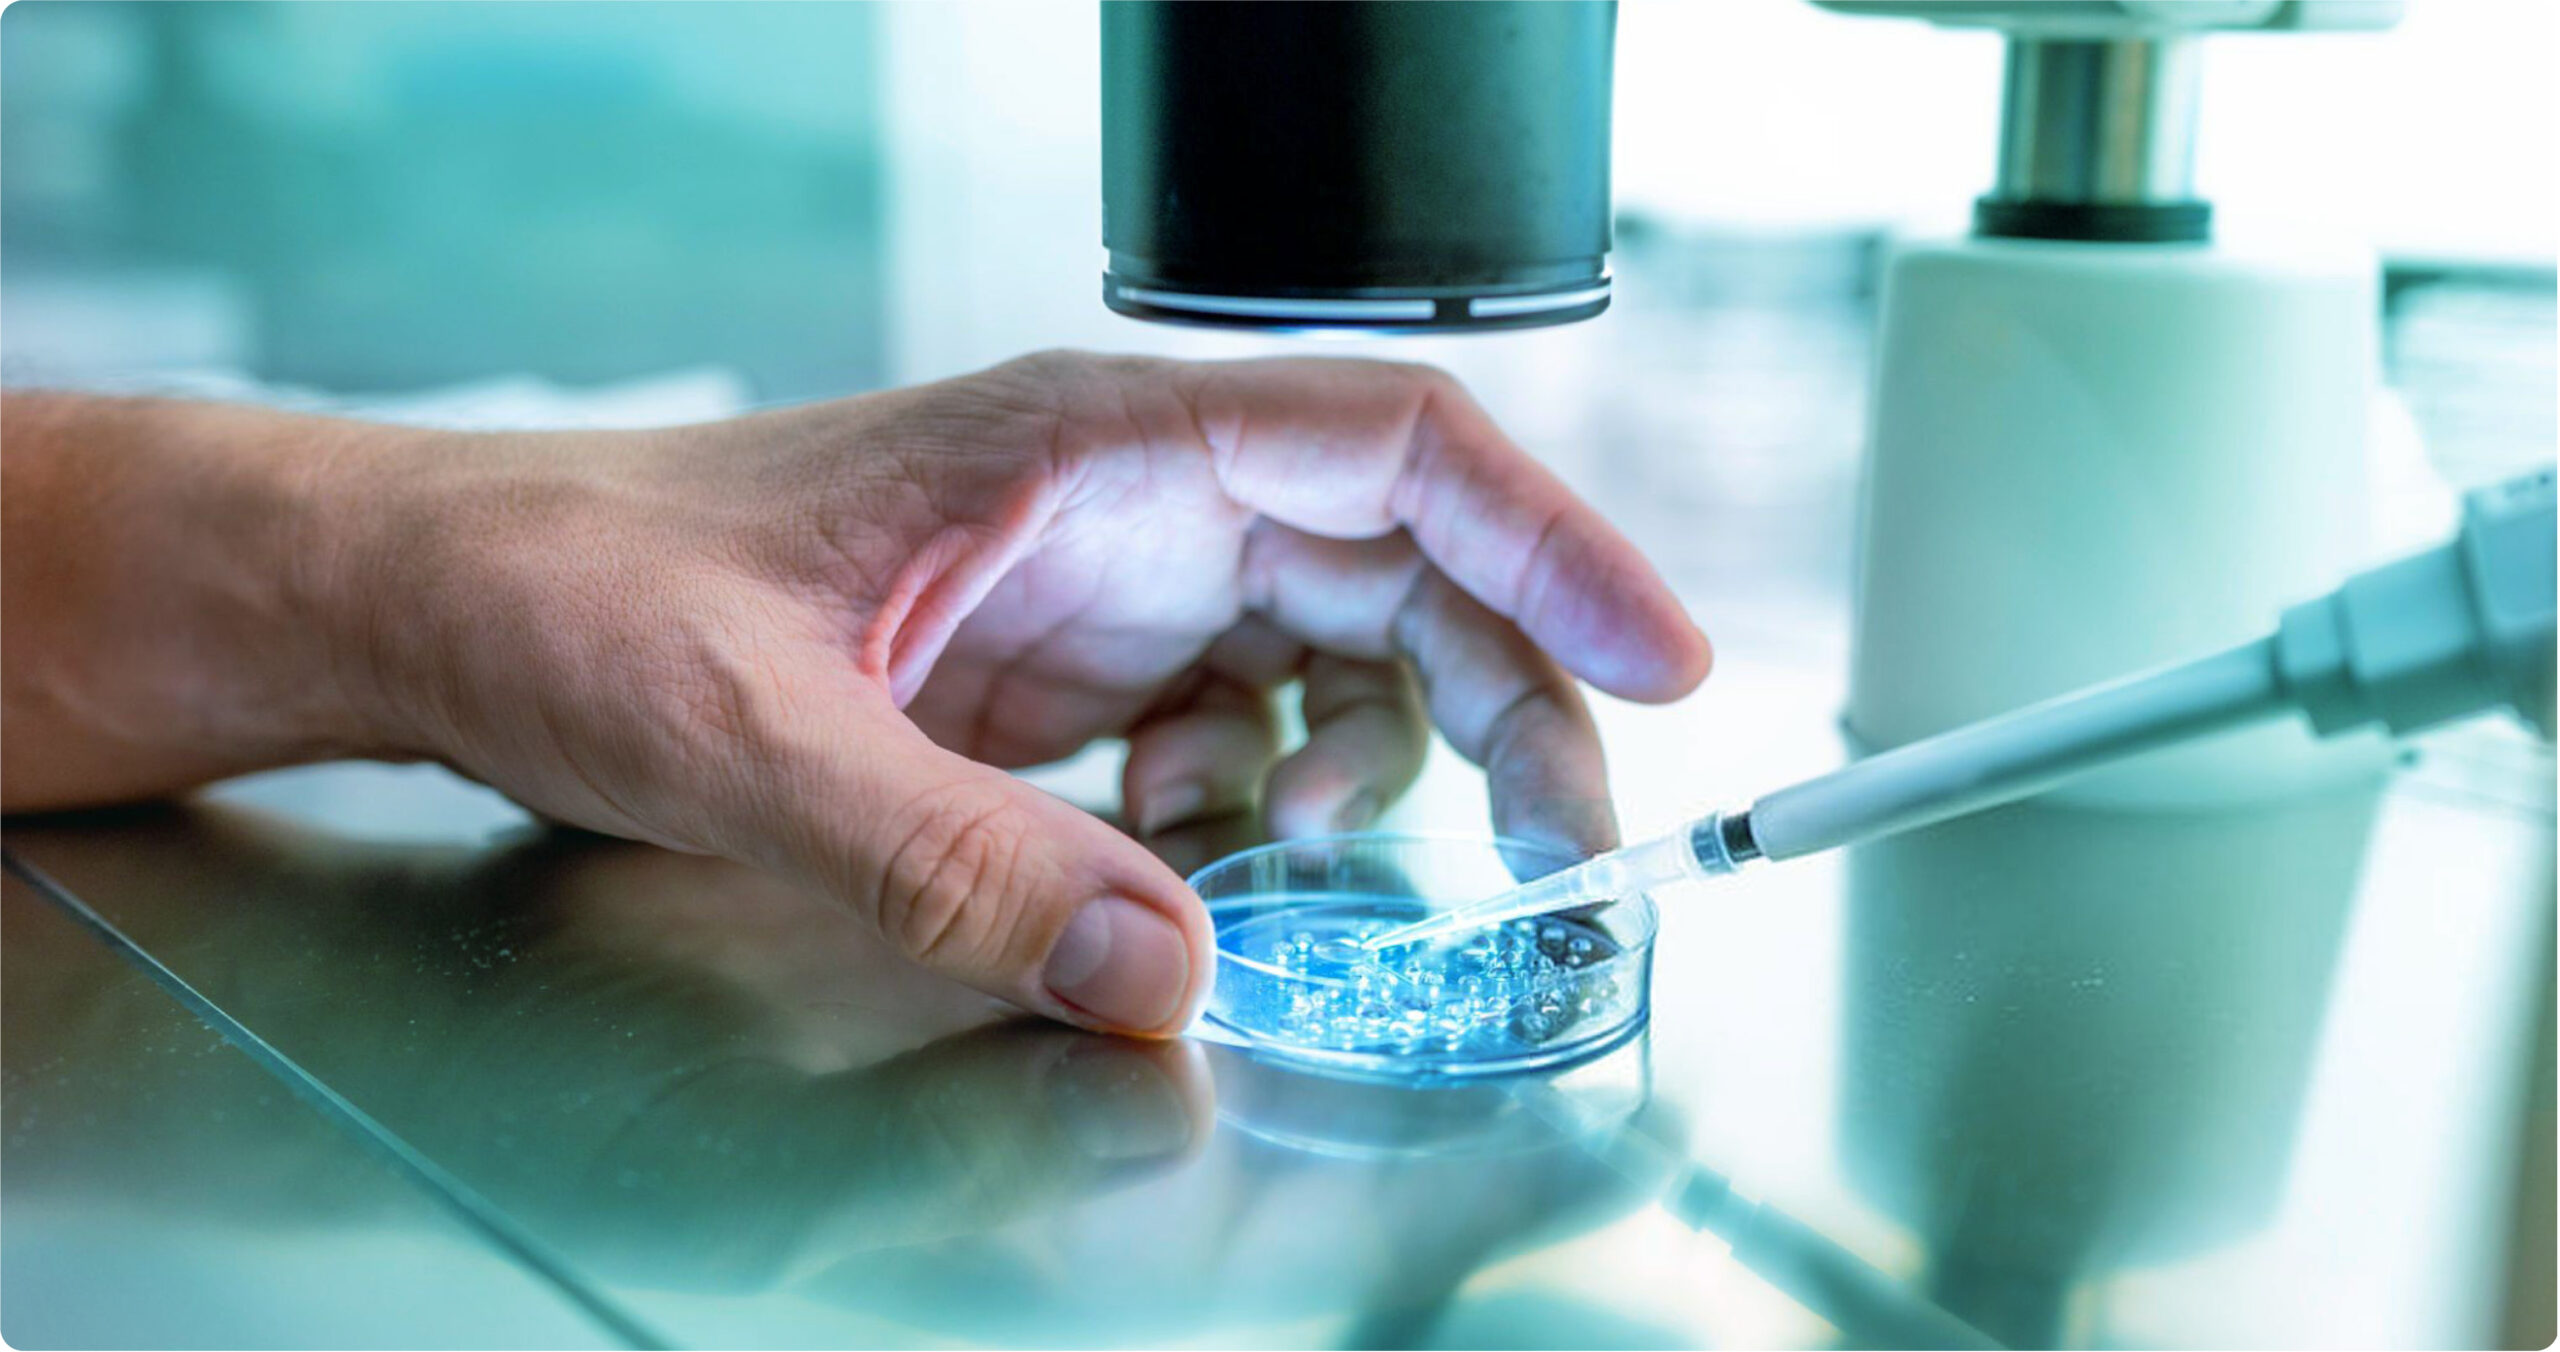

Vô sinh, hiếm muộn đã và đang là một vấn đề ngày càng phổ biến trong xã hội hiện đại. Không chỉ ảnh hưởng đến cuộc sống của các cặp đôi, mà nó còn là nỗi ám ảnh lớn về mặt tâm lý. Liệu vô sinh có chữa được không? Trong bài viết này, chúng ta sẽ đi sâu vào các phương pháp điều trị, những nguyên nhân và cách phòng ngừa vô sinh hiệu quả, với sự hỗ trợ của các chuyên gia y tế hàng đầu.
- Tình trạng vô sinh, hiếm muộn ở Việt Nam và thế giới
- Vô sinh là gì?
- Nguyên nhân vô sinh, hiếm muộn
- Dấu hiệu của vô sinh, hiếm muộn
- Vô sinh có chữa được không?
- Cách chữa vô sinh, hiếm muộn
- Câu chuyện thành công: Hành trình chữa vô sinh của chị Hồng và anh Tuấn
- Câu hỏi thường gặp về vô sinh, hiếm muộn
- Kết luận
Tình trạng vô sinh, hiếm muộn ở Việt Nam và thế giới
Thực trạng vô sinh và hiếm muộn
Hiện nay, tỷ lệ vô sinh và hiếm muộn đang tăng cao tại nhiều quốc gia trên thế giới, trong đó có Việt Nam. Ước tính, có khoảng 10-15% các cặp vợ chồng gặp khó khăn trong việc có con sau một năm chung sống. Điều này không chỉ ảnh hưởng đến chất lượng cuộc sống, mà còn tạo nên áp lực lớn về tâm lý và tài chính cho các cặp đôi.
Tầm quan trọng của việc điều trị vô sinh, hiếm muộn
Vậy vô sinh có chữa được không? Việc phát hiện và điều trị sớm các nguyên nhân gây vô sinh có thể giúp:
- Tăng cơ hội thụ thai: Điều trị đúng cách sẽ giúp cải thiện sức khỏe sinh sản và tăng khả năng mang thai.
- Cải thiện sức khỏe tổng thể: Một số phương pháp điều trị có thể giúp giảm nguy cơ mắc các bệnh liên quan đến hormone và sinh sản.
Vô sinh là gì?
Định nghĩa vô sinh theo WHO
Theo Tổ chức Y tế Thế giới (WHO), vô sinh được định nghĩa là tình trạng không thể mang thai sau:
- 12 tháng quan hệ đều đặn không sử dụng biện pháp tránh thai đối với phụ nữ dưới 35 tuổi.
- 6 tháng đối với phụ nữ từ 35 tuổi trở lên.
Phân loại vô sinh (nguyên phát và thứ phát)
- Vô sinh nguyên phát: Khi một cặp đôi chưa từng có con sau một năm cố gắng.
- Vô sinh thứ phát: Khi cặp đôi đã có con trước đây nhưng không thể có thêm con nữa.
Nguyên nhân vô sinh, hiếm muộn
Nguyên nhân từ phía nam giới
- Các rối loạn sản xuất tinh trùng: Các vấn đề về số lượng, chất lượng và khả năng di chuyển của tinh trùng đều có thể dẫn đến vô sinh. Nguyên nhân có thể là do viêm nhiễm, bệnh lý hoặc di truyền.
- Tắc nghẽn ống dẫn tinh: Tắc nghẽn ống dẫn tinh là một nguyên nhân phổ biến gây vô sinh ở nam giới, đường dẫn tinh bị tắc nghẽn nên xuất ra không có hoặc có rất ít tinh trùng.
- Các bệnh lý ảnh hưởng đến chức năng sinh sản: Các bệnh lý như viêm mào tinh hoàn, các bệnh lây qua đường tình dục hoặc viêm tuyến tiền liệt có thể ảnh hưởng nghiêm trọng đến khả năng sinh sản của nam giới.
Nguyên nhân từ phía nữ giới
- Rối loạn rụng trứng và vấn đề hormone: Các vấn đề về rối loạn rụng trứng, chẳng hạn như hội chứng buồng trứng đa nang, hoặc sự mất cân bằng hormone có thể gây khó khăn trong việc thụ thai.
- Tắc nghẽn ống dẫn trứng và các bệnh lý tử cung; Tắc nghẽn ống dẫn trứng hoặc các bệnh lý như lạc nội mạc tử cung và u xơ tử cung có thể ngăn cản trứng và tinh trùng gặp nhau.
- Các bệnh lý buồng trứng (như u nang, buồng trứng đa nang): Bệnh buồng trứng đa nang và u nang buồng trứng có thể là nguyên nhân gây ra tình trạng vô sinh ở nữ giới.
Các yếu tố nguy cơ chung ảnh hưởng đến khả năng sinh sản
- Tuổi tác và khả năng sinh sản: Tuổi tác là yếu tố quan trọng nhất ảnh hưởng đến khả năng sinh sản của cả nam và nữ. Ở nữ giới, khả năng sinh sản giảm rõ rệt sau 35 tuổi. Nam giới cũng có thể gặp khó khăn về sinh sản khi tuổi càng lớn, mặc dù tác động không rõ rệt bằng nữ giới.
- Tác động của lối sống hiện đại đến vô sinh: Lối sống hiện đại, với chế độ ăn uống không lành mạnh, ít vận động, áp lực công việc và lạm dụng các chất kích thích như rượu, thuốc lá, đều là những nguyên nhân hàng đầu gây giảm khả năng sinh sản ở cả nam và nữ.
- Các yếu tố di truyền và bệnh lý mãn tính: Một số người có thể mang các yếu tố di truyền ảnh hưởng đến khả năng sinh sản, như hội chứng Turner, hội chứng Klinefelter… Ngoài ra, các bệnh lý mãn tính như tiểu đường, béo phì cũng làm giảm khả năng thụ thai.

>>> Xem thêm: Con cái có di truyền bệnh vô sinh từ bố mẹ không?
Dấu hiệu của vô sinh, hiếm muộn
Dấu hiệu vô sinh ở nam giới
- Thay đổi về chức năng tình dục (giảm ham muốn, rối loạn cương dương): Sự suy giảm ham muốn tình dục hoặc tình trạng rối loạn cương dương là một dấu hiệu cho thấy nam giới có thể gặp vấn đề về sinh sản. Các rối loạn này có thể liên quan đến mất cân bằng hormone hoặc các vấn đề sức khỏe khác.
- Các vấn đề về tinh trùng (ít, yếu hoặc không có tinh trùng): Một số nam giới có thể gặp khó khăn do tinh trùng ít, yếu hoặc không có tinh trùng, làm giảm cơ hội thụ tinh thành công.
- Đau, sưng hoặc khối u ở vùng bìu; Nếu bạn gặp phải các triệu chứng như đau, sưng hoặc có khối u bất thường ở vùng bìu, đây có thể là dấu hiệu vô sinh ở nam giới với các vấn đề về tinh hoàn và cần được kiểm tra sớm.
Dấu hiệu vô sinh ở nữ giới
- Rối loạn chu kỳ kinh nguyệt (chu kỳ không đều, mất kinh, kinh nguyệt quá đau): Rối loạn chu kỳ kinh nguyệt là một trong những dấu hiệu đầu tiên của vô sinh ở nữ. Chu kỳ không đều, mất kinh, hoặc kinh nguyệt quá đau đều có thể là biểu hiện của các vấn đề liên quan đến rụng trứng.
- Đau bụng dưới mãn tính hoặc đau khi quan hệ: Nếu bạn gặp đau bụng dưới mãn tính hoặc đau khi quan hệ tình dục, đây có thể là dấu hiệu của các bệnh lý như lạc nội mạc tử cung hoặc viêm nhiễm phụ khoa.
- Các triệu chứng liên quan đến buồng trứng và tử cung (như rối loạn rụng trứng, lạc nội mạc tử cung, hội chứng buồng trứng đa nang); Các triệu chứng như rối loạn rụng trứng hoặc lạc nội mạc tử cung ảnh hưởng trực tiếp đến khả năng sinh sản. Đây là những vấn đề cần được thăm khám và điều trị kịp thời để đảm bảo sức khỏe sinh sản.
Vô sinh có chữa được không?
Vấn đề vô sinh là mối quan tâm của nhiều cặp đôi đang trong hành trình tìm kiếm hạnh phúc làm cha mẹ. Đặc biệt, câu hỏi “Vô sinh có chữa được không?” luôn được đặt ra và cần được giải đáp rõ ràng. Câu trả lời là: Vô sinh hoàn toàn có thể chữa được nhờ sự tiến bộ của y học hiện đại.
Trong phần này, chúng ta sẽ cùng khám phá khả năng điều trị vô sinh, tỷ lệ thành công của các phương pháp và thời điểm phù hợp để đi khám.
Tỷ lệ thành công cao: Cơ hội làm cha mẹ gần hơn bạn nghĩ
Hiện nay, với sự phát triển vượt bậc của y học, nhiều phương pháp điều trị vô sinh đã được áp dụng và mang lại tỷ lệ thành công đáng khích lệ.
Các nghiên cứu cho thấy tỷ lệ thành công của thụ tinh trong ống nghiệm (IVF) dao động từ 30% đến 50% tùy thuộc vào độ tuổi và tình trạng sức khỏe sinh sản của người vợ và người chồng. Đối với các phương pháp hỗ trợ sinh sản khác như bơm tinh trùng vào buồng tử cung (IUI) cũng có tỷ lệ thành công thường từ 15-20%
Khi nào cần đi khám vô sinh?
Nếu bạn và đối tác đã cố gắng thụ thai trong vòng 12 tháng mà không thành công (6 tháng nếu bạn trên 35 tuổi), đó là dấu hiệu cho thấy cần phải đi khám chuyên khoa để được đánh giá và tìm ra nguyên nhân.
Ngoài ra, nếu bạn có bất kỳ triệu chứng bất thường nào như rối loạn chu kỳ kinh nguyệt, đau bụng dưới mãn tính, hoặc thay đổi về chức năng sinh dục, hãy chủ động liên hệ với bác sĩ ngay.
Tầm quan trọng của việc khám sớm
Khám sớm khi gặp vấn đề về khả năng sinh sản là rất cần thiết để tăng cơ hội thành công trong việc thụ thai. Thời gian có thể là yếu tố quyết định trong hành trình tìm kiếm một đứa con và việc chậm trễ trong việc khám có thể dẫn đến những hệ quả không mong muốn. [1]
Dưới đây là một số lý do tại sao việc khám sớm lại quan trọng:
- Phát hiện sớm nguyên nhân: Nhiều nguyên nhân gây ra vô sinh có thể được phát hiện và điều trị hiệu quả nếu được phát hiện kịp thời. Việc chẩn đoán sớm giúp bác sĩ có thể đưa ra các phương án điều trị phù hợp hơn.
- Giảm thiểu rủi ro sức khỏe: Một số tình trạng sức khỏe có thể ảnh hưởng đến khả năng sinh sản, như bệnh lý buồng trứng hay viêm nhiễm, nếu không được điều trị kịp thời có thể gây ra những biến chứng nghiêm trọng hơn.
- Tăng cường tỷ lệ thành công: Các phương pháp điều trị vô sinh thường hiệu quả hơn khi được áp dụng sớm. Việc tìm kiếm sự hỗ trợ từ các chuyên gia có thể giúp cặp đôi lựa chọn được phương pháp phù hợp nhất với tình trạng của mình.
- Giải tỏa tâm lý: Khám và điều trị sớm không chỉ giúp tăng cường khả năng thụ thai mà còn giúp giảm bớt lo lắng, căng thẳng cho các cặp đôi. Sự hỗ trợ từ bác sĩ có thể mang lại cảm giác an tâm và hy vọng trong hành trình làm cha mẹ.

Cách chữa vô sinh, hiếm muộn
Điều trị vô sinh và hiếm muộn là một quá trình phức tạp và thường đòi hỏi sự kết hợp của nhiều phương pháp khác nhau. Nhiều người có chung thắc mắc Vô sinh có chữa được không? Câu trả lời là tùy thuộc vào nguyên nhân và tình trạng sức khỏe của mỗi cặp đôi, bác sĩ sẽ tư vấn phương pháp điều trị phù hợp nhất. Dưới đây là những phương pháp điều trị phổ biến:
Điều trị nội khoa
- Sử dụng thuốc điều hòa hormone: Các rối loạn hormone có thể gây ra vô sinh ở cả nam và nữ. Việc sử dụng thuốc điều hòa hormone giúp cân bằng nội tiết tố, điều chỉnh chu kỳ kinh nguyệt ở phụ nữ và cải thiện khả năng sản xuất tinh trùng ở nam giới. Một số loại thuốc thường được sử dụng bao gồm clomiphene citrate cho phụ nữ và hormone testosterone cho nam giới. [2]
- Điều trị các bệnh lý liên quan (như viêm nhiễm, bệnh lây qua đường tình dục): Nếu có các bệnh lý như viêm nhiễm, lạc nội mạc tử cung hay bệnh lây qua đường tình dục (STIs), việc điều trị triệt để các vấn đề này là rất quan trọng. Điều trị có thể bao gồm kháng sinh, thuốc kháng viêm hoặc các liệu pháp đặc hiệu để loại bỏ nguyên nhân gây ra vô sinh.
Phẫu thuật trong điều trị vô sinh
- Phẫu thuật nội soi để xử lý tắc nghẽn ống dẫn trứng, ống dẫn tinh: Trong trường hợp tắc nghẽn ống dẫn trứng ở phụ nữ hoặc ống dẫn tinh ở nam giới, phẫu thuật nội soi có thể được thực hiện để khôi phục lại thông suốt, giúp tăng khả năng thụ thai tự nhiên.
- Phẫu thuật điều trị các bệnh lý tử cung, buồng trứng: Một số bệnh lý như u xơ tử cung hay buồng trứng đa nang có thể gây khó khăn cho việc thụ thai. Các phẫu thuật như cắt bỏ u xơ hoặc phẫu thuật buồng trứng có thể giúp cải thiện khả năng sinh sản.
Công nghệ hiện đại trong hỗ trợ sinh sản
- Bơm tinh trùng vào buồng tử cung (IUI): Phương pháp này liên quan đến việc đưa tinh trùng đã được lọc rửa vào tử cung của phụ nữ trong thời điểm rụng trứng. IUI là một lựa chọn phù hợp cho các cặp đôi gặp vấn đề về tinh trùng hoặc rối loạn phóng noãn.
- Thụ tinh trong ống nghiệm (IVF): IVF là một trong những phương pháp phổ biến nhất trong điều trị vô sinh. Quá trình này bao gồm việc lấy trứng và tinh trùng từ hai vợ chồng, thụ tinh trong phòng lab và sau đó cấy phôi vào tử cung của phụ nữ.
- Tiêm tinh trùng vào bào tương trứng (ICSI): Đây là một kỹ thuật tiên tiến trong IVF, trong đó tinh trùng được tiêm trực tiếp vào bào tương của trứng, giúp tăng cường khả năng thụ tinh cho những trường hợp có vấn đề với chất lượng tinh trùng.
- Trưởng thành trứng non và lưu trữ giao tử: Kỹ thuật này cho phép bác sĩ nuôi trứng non trong môi trường thích hợp và sau đó kết hợp với tinh trùng tạo thành phôi hoặc lưu trữ để sử dụng sau này, giúp tăng cơ hội thụ thai.

Điều chỉnh lối sống để cải thiện khả năng sinh sản
- Chế độ ăn uống và tập luyện: Một chế độ ăn uống cân đối, giàu dinh dưỡng cùng với việc duy trì hoạt động thể chất đều đặn sẽ giúp cải thiện sức khỏe sinh sản. Các thực phẩm giàu vitamin, khoáng chất và chất chống oxy hóa có thể hỗ trợ quá trình thụ thai. [3]
- Giảm stress và duy trì cân nặng hợp lý: Căng thẳng và thừa cân có thể ảnh hưởng tiêu cực đến khả năng sinh sản. Việc thực hiện các biện pháp giảm stress như yoga, thiền và duy trì cân nặng trong khoảng lý tưởng có thể giúp cải thiện tình trạng sức khỏe sinh sản.
- Hạn chế các chất gây hại (thuốc lá, rượu bia): Hút thuốc và tiêu thụ rượu bia có thể gây ra nhiều vấn đề về sức khỏe sinh sản. Các cặp đôi nên hạn chế hoặc từ bỏ các thói quen này để tối ưu hóa khả năng thụ thai.
Câu chuyện thành công: Hành trình chữa vô sinh của chị Hồng và anh Tuấn
Niềm tin cuối cùng đã được đền đáp
Chị Hồng và anh Tuấn, một cặp vợ chồng từ Hà Nội, bước vào cuộc hôn nhân với tất cả niềm hy vọng về một gia đình hạnh phúc. Khi kết hôn ở tuổi 30, họ háo hức mong chờ đứa con đầu lòng sẽ sớm xuất hiện để làm trọn vẹn tổ ấm. Thế nhưng, thời gian trôi qua, từng tháng rồi từng năm, hy vọng mong manh dần nhường chỗ cho lo lắng. Họ cũng từng lo lắng, tự hỏi nhau, liệu vô sinh có chữa được không?
Sau 3 năm cố gắng mà không có dấu hiệu mang thai, họ quyết định đến gặp bác sĩ Tăng Đức Cương – chuyên gia về vô sinh và hiếm muộn. Kết quả kiểm tra khiến họ bất ngờ. Chị Hồng được chẩn đoán mắc hội chứng buồng trứng đa nang – một tình trạng khiến trứng không rụng đều đặn, gây cản trở quá trình thụ thai. Cùng lúc đó, anh Tuấn cũng đối diện với một sự thật khó chấp nhận: số lượng và chất lượng tinh trùng của anh không đạt yêu cầu. Hai người đều phải đối mặt với vấn đề vô sinh – điều mà họ chưa từng nghĩ đến.

Ban đầu, cú sốc này khiến họ vô cùng hoang mang. Nhiều câu hỏi xuất hiện trong tâm trí họ: “Liệu mình có bao giờ được làm cha mẹ không?”, “Chúng ta phải làm gì tiếp theo? Cuối cùng, chị Hồng và anh Tuấn quyết định bước vào hành trình chữa vô sinh với niềm hy vọng mong manh.
Chị Hồng Bắt đầu bằng các phương pháp điều trị nội khoa được kê đơn thuốc và tiêm hormone để điều hòa chu kỳ kinh nguyệt, tăng khả năng thụ thai tự nhiên. Sau nhiều tháng điều trị nhưng không có kết quả, bác sĩ Tăng Đức Cương đề xuất họ tiến hành thụ tinh trong ống nghiệm (IVF). Chị Hồng và anh Tuấn hiểu rằng đây là cơ hội cuối cùng của họ, nhưng điều đó cũng đồng nghĩa với nhiều thử thách hơn.
Sau hai lần chuyển phôi thất bại, niềm vui cuối cùng cũng đến với chị Hồng trong lần chuyển phôi thứ ba. Khoảnh khắc nhận kết quả dương tính từ bác sĩ Tăng Đức Cương, họ không kìm được nước mắt.
Giờ đây, mỗi lần nhìn ngắm đứa con bé bỏng trong vòng tay, chị Hồng và anh Tuấn biết rằng hành trình chữa vô sinh của họ, dù có dài và đầy thử thách, là hoàn toàn xứng đáng. Câu hỏi vô sinh có chữa được không? họ từng hỏi nhau đã có câu trả lời.
Bài học từ hành trình chữa vô sinh
- Niềm tin và kiên trì: Không dễ dàng để vượt qua những thất bại, nhưng kiên trì là chìa khóa.
- Tìm đến bác sĩ chuyên gia: Lựa chọn một bác sĩ giỏi và đáng tin cậy là yếu tố quyết định thành công.
Câu hỏi thường gặp về vô sinh, hiếm muộn
Tại sao chữa vô sinh lại lâu và tốn kém?
Điều trị vô sinh phụ thuộc vào nhiều yếu tố như nguyên nhân, phương pháp và cơ sở y tế. Các phương pháp công nghệ cao như IVF hoặc ICSI cần đội ngũ chuyên gia và thiết bị hiện đại, dẫn đến chi phí cao.
Có cách nào để chọn giới tính em bé không?
Một số kỹ thuật như lựa chọn phôi khi IVF có thể tăng khả năng chọn giới tính, nhưng điều này cần tuân thủ quy định pháp luật từng quốc gia. [4]
Sau điều trị vô sinh có thể mang thai tự nhiên không?
Có, nhiều cặp đôi đã thành công mang thai tự nhiên sau khi điều trị thành công các vấn đề gây vô sinh.
Các thủ thuật hỗ trợ sinh sản có đau không? Có cách nào để giảm bớt cảm giác đau không?
Các thủ thuật hỗ trợ sinh sản thường được thực hiện dưới gây tê hoặc gây mê, giúp giảm thiểu cảm giác đau một cách tối đa. Ngoài ra, bác sĩ sẽ hướng dẫn và tư vấn cho bạn những biện pháp giảm đau trước và sau khi thực hiện thủ thuật để bạn cảm thấy thoải mái hơn.
Bao lâu không có thai thì nên đi khám?
- Dưới 35 tuổi: Sau 12 tháng không sử dụng biện pháp tránh thai.
- Trên 35 tuổi: Sau 6 tháng.
Kết luận
Vô sinh có chữa được không? Câu trả lời là hoàn toàn có thể! Nhờ những tiến bộ vượt bậc của y học, đặc biệt là các kỹ thuật hỗ trợ sinh sản như bơm tinh trùng vào buồng tử cung, thụ tinh trong ống nghiệm, giấc mơ làm cha mẹ của bạn đang ngày càng trở nên gần hơn.
Hành trình điều trị vô sinh có thể không hề dễ dàng, nhưng với niềm tin và nỗ lực không ngừng, bạn hoàn toàn có thể chạm tới giấc mơ làm cha mẹ. Hãy mạnh dạn chia sẻ cảm xúc của mình và tìm kiếm sự hỗ trợ từ bác sĩ cũng như những người thân yêu xung quanh.
Nếu bạn đang tìm kiếm một chuyên gia giàu kinh nghiệm để đồng hành cùng mình, hãy liên hệ ngay với bác sĩ Tăng Đức Cương. Bác sĩ sẽ giúp bạn xác định nguyên nhân và tư vấn các phương pháp điều trị phù hợp nhất để hỗ trợ bạn trong hành trình này.
(Chúng tôi đã nhận được sự cho phép của nhân vật để kể lại câu chuyện này. Để bảo vệ thông tin cá nhân, tên của nhân vật đã được thay đổi.)

